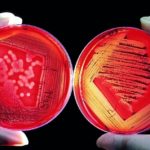

Singles-Domains für den Singles-Day
Den Anfang machte China. Internetworld.de berichtet: "Der Singles Day am 11.11. galt in China unter Studenten ursprünglich als eine Art Anti-Valentinstag für Alleinstehende, weil das Datum nur aus Einsen besteht. Vor acht Jahren begann dann Alibaba seinen Kunden an diesem Mehr